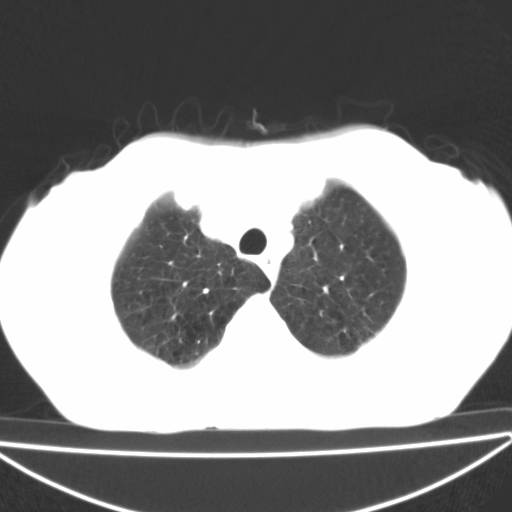
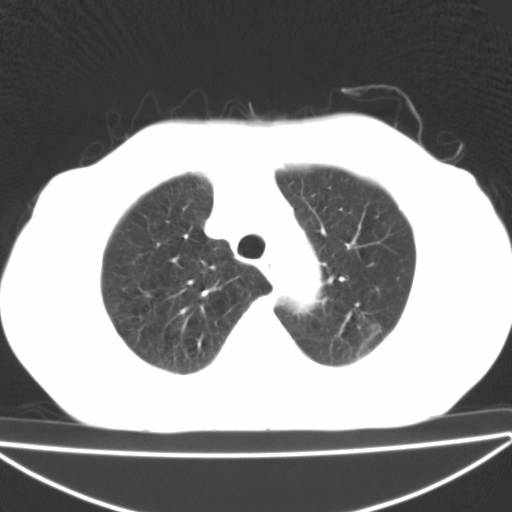
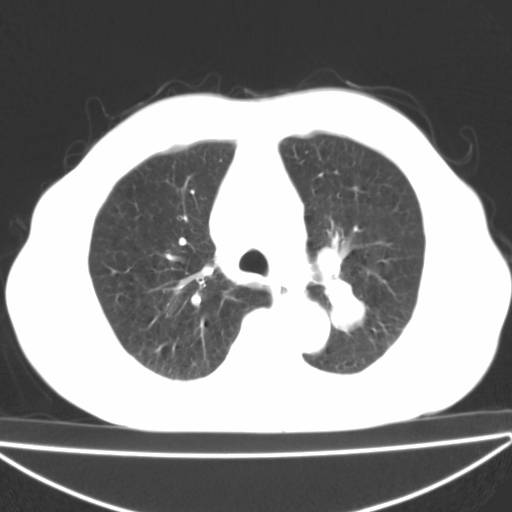
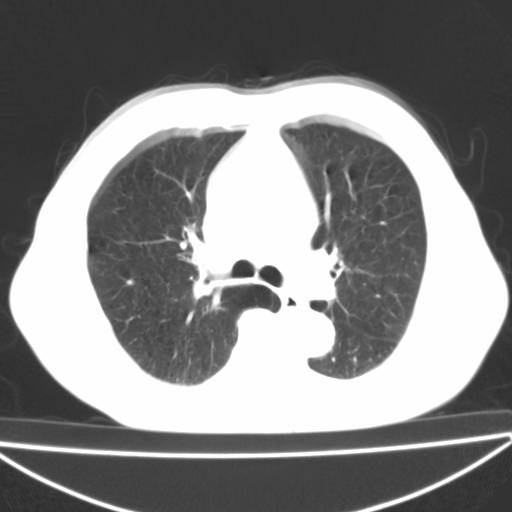
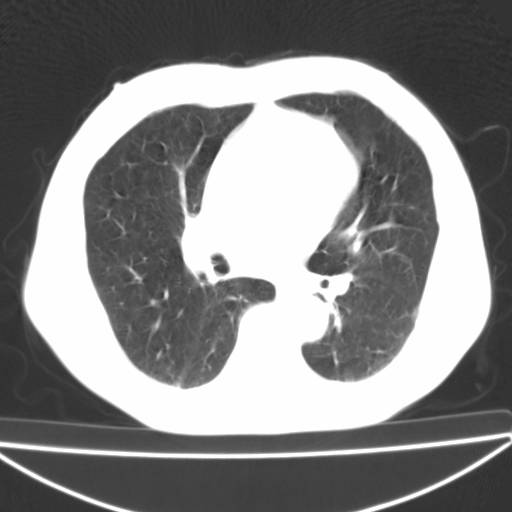
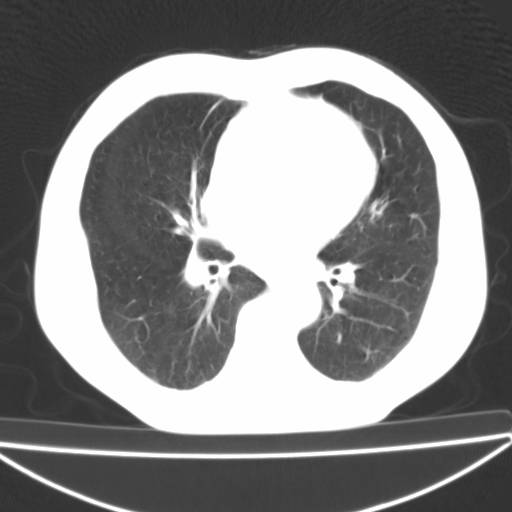
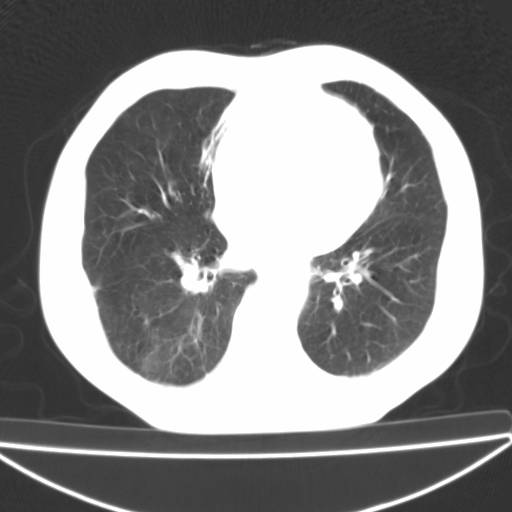

以下是引用zjzjr在2006-12-6 19:04:00的发言:[br]左肺上叶尖后段可见椭圆形高密度影,其内可见点状钙化影,周围可见卫星病灶.首先考虑结核,双侧少量胸腔积液.
以下是引用李世军在2006-12-6 19:54:00的发言:[br]左肺上叶尖后段可见椭圆形高密度影,其内可见点状钙化影,周围可见卫星病灶.首先考虑结核,双侧少量胸腔积液. [br] [br] 双肺轻度肺气肿,左肺上叶后段见多发斑片状密度增高影,周围见少许斑点状卫星病灶,双侧胸膜增厚粘连,纵隔内未见明显改变,考虑结核可能性大,请结合临床或增强扫描. [br] [br]

以下是引用13081830109在2006-12-6 19:35:00的发言:[br]左肺上叶尖后段可见椭圆形高密度影,其内可见点状钙化影,周围可见卫星病灶.首先考虑结核,双侧少量胸腔积液.
以下是引用守望可可西里在2006-12-7 0:01:00的发言:[br][quote]以下是引用zjzjr在2006-12-6 19:04:00的发言:[br]左肺上叶尖后段可见椭圆形高密度影,其内可见点状钙化影,周围可见卫星病灶.首先考虑结核,双侧少量胸腔积液.
| 欢迎光临 医影在线 (http://bbs.radida.com/bbs/) | Powered by Discuz! X3.2 |